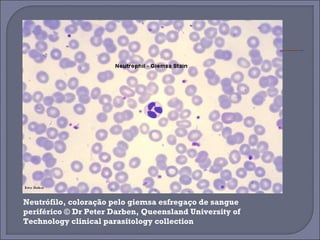
Neutrófilo, coloração pelo giemsa esfregaço de sangue 
periférico © Dr Peter Darben, Queensland University of 
Technology clinical parasitology collection
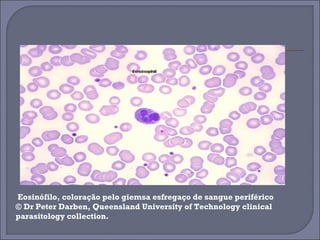
Eosinófilo, coloração pelo giemsa esfregaço de sangue periférico 
© Dr Peter Darben, Queensland University of Technology clinical 
parasitology collection.
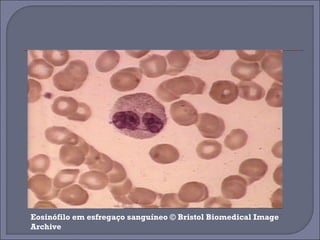
Eosinófilo em esfregaço sanguíneo © Bristol Biomedical Image 
Archive
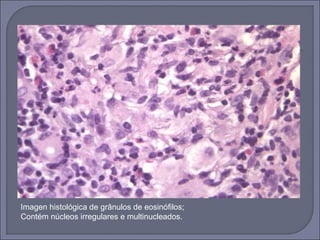
Imagen histológica de grânulos de eosinófilos; 
Contém núcleos irregulares e multinucleados.

O documento descreve as características e funções dos neutrófilos e eosinófilos, que são tipos de glóbulos brancos. Os neutrófilos são os mais numerosos e desempenham um papel importante na defesa contra infecções bacterianas através de grânulos que contêm enzimas bactericidas. Já os eosinófilos constituem menos de 4% dos glóbulos brancos e estão envolvidos na defesa contra parasitas e em reações alérgicas devido a grânulos que se coram em rosa-